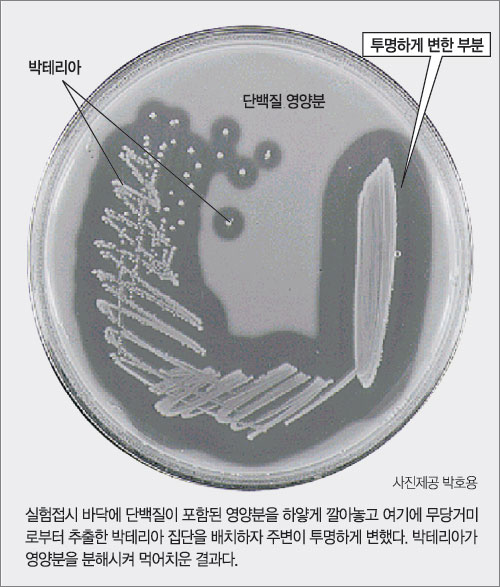

공유하기
사람 살리는 벌레들…약물개발 사례 세계서 주목
-
입력 2004년 10월 14일 19시 04분
글자크기 설정

● 무당거미의 소화능력 모방
‘한국의 스파이더맨 벌레를 산업화시키다.’ 경제전문지 ‘파이스턴이코노믹리뷰(FEER)’가 한국의 곤충산업이 세계적인 주목을 받고 있다면서 지난달 30일자 제목으로 소개한 내용이다.
‘한국의 스파이더맨’은 한국생명공학연구원의 곤충자원연구실 박호용 실장(47)을 가리키는 말. 한국에 흔한 무당거미에서 특별한 단백질(효소)을 분비하는 박테리아(Aranicola proteolyticus)를 찾아냈고, 이를 활용해 미국 중국 등에 수출 계약을 활발하게 체결하고 있다. 무당거미에서 무엇을 발견한 것일까.
일반적으로 거미줄에 먹이가 걸려들면 거미는 슬슬 다가가 침을 꽂고 액체를 주입한다. 이 액체에는 먹이를 꼼짝 못하게 만드는 강력한 마취 성분은 물론 내부 기관을 흐물흐물하게 녹여버리는 ‘소화제’가 들어 있다. 남은 일은 힘들이지 않고 먹이를 ‘후루룩’ 빨아먹는 일.
박 실장은 거미의 몸속에 ‘소화제’를 만들어내는 박테리아가 있지 않을까 생각했다. 사람도 위나 대장에 사는 박테리아들이 음식을 효과적으로 분해하지 않는가. 사실 누구나 떠올릴 수 있는 생각이지만 이를 실행에 옮긴 사람은 박 실장이 처음이다. 그는 1994년 연구에 착수해 6년간의 연구 끝에 박테리아로부터 고효율의 분해효소(아라자임)를 분리해냈다.
박 실장은 “아라자임은 소금기가 많거나 섭씨 40도의 고온 등 혹독한 조건에서도 기능을 발휘한다”며 “단순히 소화뿐 아니라 항생 효과도 발견돼 활용할 분야가 무궁무진하다”고 말했다. 항생 효과는 거미가 독성을 가진 먹이를 섭취했을 때 자신을 보호하려고 갖춘 능력.
● 더러운 곳에 사는 애벌레의 비결
일반적으로 애벌레는 더러운 환경에서도 잘 적응해 살아간다. 뒤집어 얘기하면 신체의 방어 메커니즘(면역체계)이 잘 발달해 있다는 의미.
대표적인 사례가 상처 난 피부를 보호하고 딱지가 잘 생기게 하는 ‘멜라닌’이란 물질을 만들어내는 일이다. 이 능력은 사람보다 애벌레가 훨씬 뛰어나기 때문에 세계 과학자들이 애벌레 연구에 몰두하고 있다. 천연 항생제나 소염제를 만들 수 있는 물질을 추출하기 위해서다. 만일 멜라닌 생성을 억제할 수 있다면 피부를 하얗게 만드는 ‘미백제’ 개발도 가능하기 때문에 화장품 업계에서도 관심이 많다.
이 분야에서 선두주자를 달리는 프랑스, 스웨덴, 미국, 일본 등에선 이미 관련 제품들이 쏟아져 나오고 있다. 한국도 뒤지지 않고 있다. 한 예로 생명연은 1994년부터 프랑스 파스퇴르연구소와 공동으로 벌레의 면역체계에 대한 연구를 진행해오고 있다. 대상은 나방 애벌레. 조만간 효과가 뛰어난 시제품이 등장할 예정이다.
또 부산대 약학대 이복률 교수 연구팀은 딱정벌레의 애벌레에서 세균 감염 여부를 진단할 수 있는 물질을 찾아냈다. 이 물질은 세균이 애벌레에 침입했을 때 이를 감지하고 분해하는 역할을 수행한다. 연구팀은 실제로 이 물질을 이용한 진단시약을 개발해 상품화시켰다.
●한의학에서 얻은 약용 성분
생명연 연구원들이 창업한 바이오벤처 ‘인섹트바이오텍’은 농작물 해충인 반묘, 죽어서 회색빛을 띠는 누에인 백강잠 등 한의학에서 사용되는 벌레들에 관심이 많다. 이들로부터 고지혈증이나 심장순환기질환 치료에 좋은 생약성분을 추출할 수 있기 때문이다. 최근까지 동물 실험에서 상당한 효과를 봤고, 그 연구 결과를 ‘한국생약학회지’ 최신호에서 선보일 예정이다.
지구에 존재한다고 알려진 벌레는 약 100만종. 이 가운데 국내에 살고 있는 것은 불과 12만종이다. 그래서 세계 최대의 생물종을 보유한 중국이나 브라질과 국제공동연구가 추진되고 있다. 세계 곳곳의 독특한 환경에서 벌레를 많이 발견할수록 인간이 건강하게 장수를 누릴 수 있는 시기가 앞당겨지지 않을까.
|
박근태 동아사이언스 기자 kunta@donga.com
김훈기 동아사이언스 기자 wolfkim@donga.com
트렌드뉴스
-
1
‘찐명’ 한준호, 김어준 직격 “지라시도 안되는 음모론으로 李정부 공격”
-
2
“머리 감기기 힘들다” 의식없는 노모 삭발한 간병인, 격분한 딸이 폭행
-
3
“실수 봐준 고깃집에 돈쭐 내주자”…인부 18명이 고기 주문
-
4
SK하이닉스 “6세대 LPDDR6 세계 첫 개발”…모바일용 D램도 고도화
-
5
‘독도 마지막 주민’ 김신열 씨 별세…등록된 민간인 ‘0명’
-
6
‘빌런’ 취급 받던 약사, 32살에 ADHD 진단…“왜 괴로웠는지 알게 돼”
-
7
대북송금 검사 “檢지휘부 믿다 나는 죽고 사건은 취소될 판”
-
8
초밥용 식초 달랬더니 락스 내준 횟집…“위 세척할 뻔” [e글e글]
-
9
트럼프가 꽂힌 구두…“백악관 모든 남자가 그걸 신느라 진땀”
-
10
장동혁, ‘후보 미등록’ 김태흠 찾아가 “공천 신청해달라”
-
1
의총서 침묵한 장동혁…‘절윤 결의문’엔 “총의 존중”
-
2
장동혁 “의원들 의견 잘 들었다”…‘절윤’ 입장 이틀째 침묵
-
3
李 “주한미군 무기 반출, 반대의견 내지만 관철 어려워”
-
4
한동훈 “尹 복귀 반대 결의?…어차피 감옥 있는데 그게 절연인가”
-
5
성토 쏟아져도 침묵한 장동혁, 절윤 결의문엔 대변인 짧은 입장만
-
6
성토 쏟아져도 침묵한 張, 절윤 결의문엔 대변인 짧은 입장만
-
7
‘찐명’ 한준호, 김어준 직격 “지라시도 안되는 음모론으로 李정부 공격”
-
8
李 “개혁하자고 초가삼간 태우면 안돼” 檢개혁 정부 주도 못박아
-
9
전한길 “내 덕에 대표 된 장동혁, 윤어게인이냐 절윤이냐 밝혀라”
-
10
대북송금 검사 “檢지휘부 믿다 나는 죽고 사건은 취소될 판”
트렌드뉴스
-
1
‘찐명’ 한준호, 김어준 직격 “지라시도 안되는 음모론으로 李정부 공격”
-
2
“머리 감기기 힘들다” 의식없는 노모 삭발한 간병인, 격분한 딸이 폭행
-
3
“실수 봐준 고깃집에 돈쭐 내주자”…인부 18명이 고기 주문
-
4
SK하이닉스 “6세대 LPDDR6 세계 첫 개발”…모바일용 D램도 고도화
-
5
‘독도 마지막 주민’ 김신열 씨 별세…등록된 민간인 ‘0명’
-
6
‘빌런’ 취급 받던 약사, 32살에 ADHD 진단…“왜 괴로웠는지 알게 돼”
-
7
대북송금 검사 “檢지휘부 믿다 나는 죽고 사건은 취소될 판”
-
8
초밥용 식초 달랬더니 락스 내준 횟집…“위 세척할 뻔” [e글e글]
-
9
트럼프가 꽂힌 구두…“백악관 모든 남자가 그걸 신느라 진땀”
-
10
장동혁, ‘후보 미등록’ 김태흠 찾아가 “공천 신청해달라”
-
1
의총서 침묵한 장동혁…‘절윤 결의문’엔 “총의 존중”
-
2
장동혁 “의원들 의견 잘 들었다”…‘절윤’ 입장 이틀째 침묵
-
3
李 “주한미군 무기 반출, 반대의견 내지만 관철 어려워”
-
4
한동훈 “尹 복귀 반대 결의?…어차피 감옥 있는데 그게 절연인가”
-
5
성토 쏟아져도 침묵한 장동혁, 절윤 결의문엔 대변인 짧은 입장만
-
6
성토 쏟아져도 침묵한 張, 절윤 결의문엔 대변인 짧은 입장만
-
7
‘찐명’ 한준호, 김어준 직격 “지라시도 안되는 음모론으로 李정부 공격”
-
8
李 “개혁하자고 초가삼간 태우면 안돼” 檢개혁 정부 주도 못박아
-
9
전한길 “내 덕에 대표 된 장동혁, 윤어게인이냐 절윤이냐 밝혀라”
-
10
대북송금 검사 “檢지휘부 믿다 나는 죽고 사건은 취소될 판”
-
- 좋아요
- 0개
-
- 슬퍼요
- 0개
-
- 화나요
- 0개



댓글 0